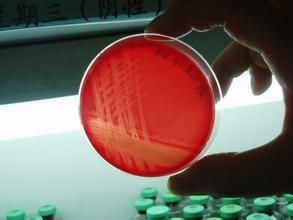
溶血隱秘桿菌

形態描述
 溶血隱秘桿菌
溶血隱秘桿菌模式種
溶血隱秘桿菌(Arcanobacteriumhaemolyticum)。溶血隱秘桿菌屬於隱秘桿菌屬,為兼性厭氧菌,此菌在實驗室中檢出率較低,生長緩慢,我院檢驗科從一患者腹部傷口分泌物中分離出1株溶血隱秘桿菌。

溶血隱秘桿菌屬於隱秘桿菌屬,為兼性厭氧菌,此菌在實驗室中檢出率較低,生長緩慢。
溶血隱秘桿菌
溶血隱秘桿菌溶血隱秘桿菌(Arcanobacteriumhaemolyticum)。溶血隱秘桿菌屬於隱秘桿菌屬,為兼性厭氧菌,此菌在實驗室中檢出率較低,生長緩慢,我院檢驗科從一患者腹部傷口分泌物中分離出1株溶血隱秘桿菌。
